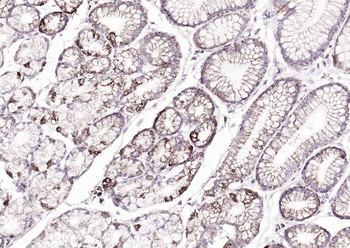
ATP7B Rabbit Polyclonal Antibody

You have no items in your shopping cart.
All Products
- GSK-3 Beta Mouse Monoclonal Antibody [orb500627]Featured

IF, IHC-Fr, IHC-P, WB
Human, Mouse, Rat
Mouse, Rat
Mouse
Monoclonal
Unconjugated
200 μg, 50 μl, 100 μl, 200 μl - MEK2 Mouse Monoclonal Antibody [orb499566]Featured

IF, IHC-Fr, IHC-P, WB
Human, Mouse, Rat
Mouse, Rat
Mouse
Monoclonal
Unconjugated
200 μl, 50 μl, 100 μl, 200 μg - Bcl-2 Mouse Monoclonal Antibody [orb499778]Featured

ICC, IF, IHC-Fr, IHC-P, WB
Human, Rat
Bovine, Canine, Equine, Guinea pig, Mouse, Porcine, Rabbit, Sheep
Mouse
Monoclonal
Unconjugated
200 μg, 200 μl, 50 μl, 100 μl - CALB1 Rabbit Polyclonal Antibody [orb182649]Featured

ICC, IF, IHC-Fr, IHC-P, WB
Human, Mouse, Rat
Bovine, Canine, Equine, Porcine, Rabbit
Rabbit
Polyclonal
Unconjugated
50 μl, 100 μl, 200 μl - CDCA5 Rabbit Polyclonal Antibody [orb101397]Featured

FC, IF, IHC-Fr, IHC-P
Human, Mouse, Rat
Bovine, Canine, Equine, Porcine, Rabbit
Rabbit
Polyclonal
Unconjugated
100 μl, 50 μl, 200 μl - Klotho Rabbit Polyclonal Antibody [orb101064]Featured

IF, IHC-Fr, IHC-P, WB
Human, Mouse, Rat
Bovine, Canine, Equine, Porcine, Rabbit
Rabbit
Polyclonal
Unconjugated
100 μl, 200 μl, 50 μl - HSP70 Rabbit Polyclonal Antibody [orb157591]Featured

FC, ICC, IF, IHC-Fr, IHC-P, WB
Human, Mouse, Rat
Bovine, Gallus, Porcine, Rabbit, Sheep
Rabbit
Polyclonal
Unconjugated
50 μl, 100 μl, 200 μl - Caspase-3 Rabbit Polyclonal Antibody [orb10237]Featured

ELISA, WB
Human, Mouse, Rat
Mouse, Rat
Rabbit
Polyclonal
Unconjugated
50 μl, 100 μl - ASCL1 Rabbit Polyclonal Antibody [orb10143]Featured

FC, ICC, IF, IHC-Fr, IHC-P, WB
Human, Mouse, Rat
Bovine, Sheep
Rabbit
Polyclonal
Unconjugated
50 μl, 100 μl, 200 μl - ATP7B Rabbit Polyclonal Antibody [orb10160]Featured

IF, IHC-Fr, IHC-P
Human, Mouse, Rat
Gallus, Porcine, Rabbit
Rabbit
Polyclonal
Unconjugated
50 μl, 100 μl, 200 μl